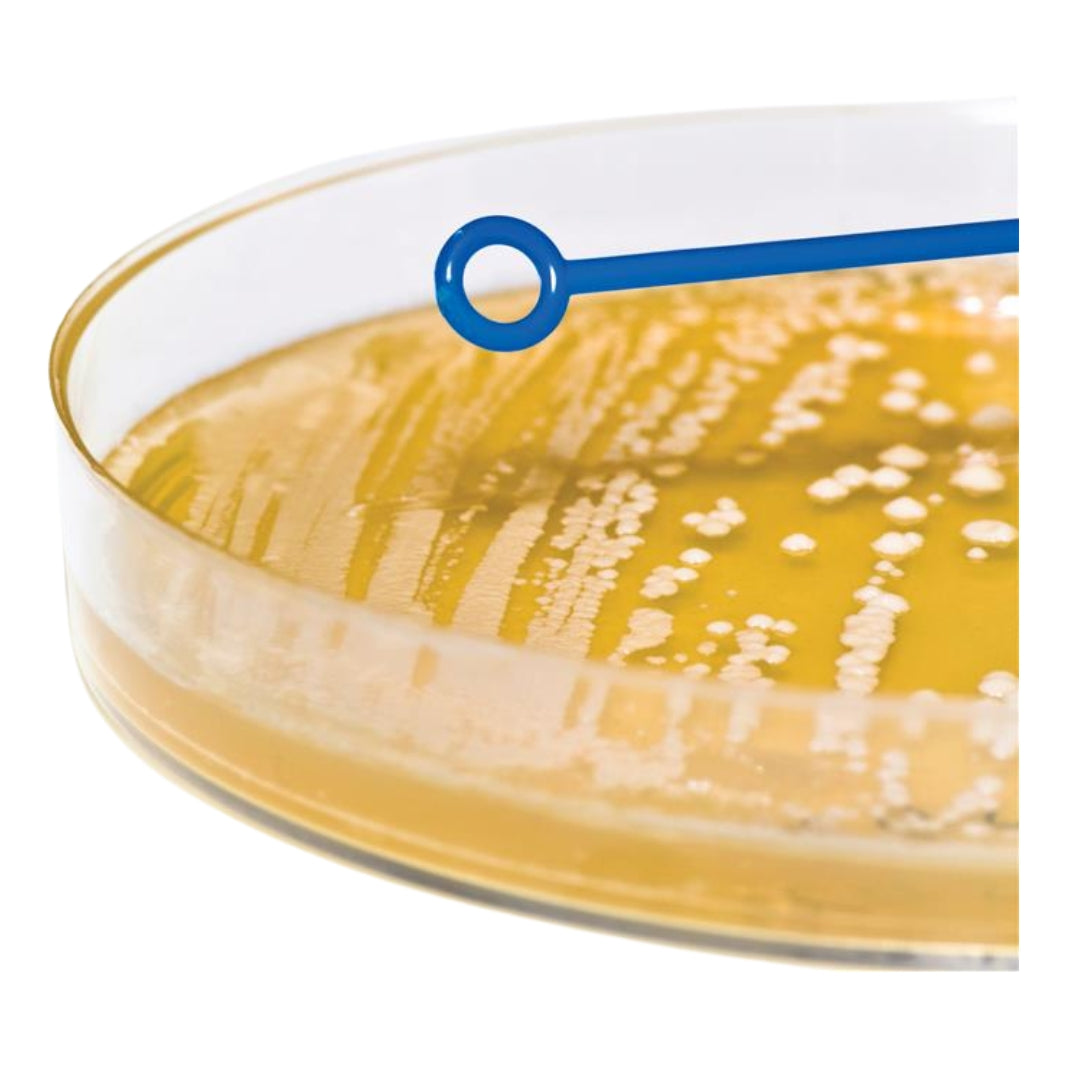
Asa de Siembra Bacteriológica

Asa de Siembra Bacteriológica
Asa de Siembra Bacteriológica
Precio habitual
S/. 12.00 PEN
Precio habitual
Precio de oferta
S/. 12.00 PEN
Precio unitario
/
por
Las Asas de Siembra estériles y desechables son dispositivos para la inoculación de microorganismos (como bacterias o levaduras), en medios de crecimiento que pueden estar en placa o en tubo antes de la incubación, multiplicación y crecimiento. Idóneas para ser utilizadas en cabinas de flujo laminar, campanas de seguridad o en condiciones que requieran esterilidad y no sea posible flamear el asa. Fabricadas en plástico de poliestireno, su alta flexibilidad y la superficie libre de rugosidades del asa aseguran un suave deslizamiento sin peligro de dañar la superficie del medio de cultivo
|
Presentación |
Dimensiones |
|
Paquete x 10 unidades |
1ul |
|
Paquete x 10 unidades |
10ul |